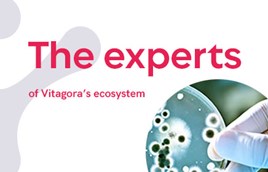

21 November 2019 / The experts of the Vitagora ecosystem / Vitagora publication / Science and technologies
Analysing nanomaterials to ensure your products are labelled correctly
This article is also available in French:
Why this should interest you
- Correct identification of nanomaterials is critical for meeting regulatory requirements, traceability and accurate labelling for food.
- It also provides necessary knowledge about substances used for risk management when necessary.
- However, current analytical techniques are not necessarily adapted to substances tested.
Nanomaterials and additives containing nanoparticles are now widely used by the food industry for their unique properties: improving ingredients, optimising manufacturing processes, and creating packaging with advanced properties. In a context where the risks related to complex nanomaterials require complex understanding, and the media has amplified underlying fears, French authorities have imposed regulations on labelling featuring nanomaterials in ingredients since December 2014 (INCO Regulation – learn more here).
As a result, it is imperative to be able to determine whether a particulate substance should be considered a nanomaterial – or not. However, not all analytical techniques available to the food industry are necessarily adapted to the substances tested. How can you be sure substances are correctly tested, to in turn ensure accurate labels for the consumer and compliance with regulations? Georges Favre, director of the LNE Nanotech Institute explains.
Georges Favre
A graduate of the Ecole Centrale Paris (2005) and doctor of analytical chemistry (2008), Georges Favre joined the National Laboratory of Metrology and Tests (LNE) in 2011 in research management. He was named product manager of nanomaterials in 2015. At the same time, he led a nanometrology network of 400 members to provide a link between the academic community and industry for nanometre-scale characterisation issues. In 2017, he became director of the LNE Nanotech Institute and is now responsible for coordinating all LNE activities related to nanomaterials and nanotechnologies. Since 2019, he has been co-president of the AFNOR/X457 standardisation committee in charge of nanotechnologies and nanomaterials.
LNE
A public industry and commercial institution (EPIC), the LNE is governed by the Ministry of Economy and Finance in charge of Industry. Based on scientific and technical excellence, and home to the French National Laboratory of Metrology in charge of the development of references for measurement, i.e. reference methods/standards, the LNE covers multiple applications including calibrations, tests and certification. Recognised in France and internationally, the LNE provides measurement expertise for the economy and society. Since its creation in 1901, the LNE has been working for a safer society with more competitive and innovative companies. Learn more at lne.fr.
What is a nanomaterial?
"There exist several definitions for nanomaterials with different criteria in France and Europe," explains Georges Favre. "If a substance is to be identified as a nanomaterial, it is important to know which definition to refer to.”
Regulation No. 2283/2015 uses concepts of intentionality of production or properties typical of nanoscale (i.e. 1- 100 nm). However, the approach adopted in the European Commission’s recommended definition (2011/696/EU), intended for long-term harmonisation of concepts, uses number size distribution, in an unbound state or as an aggregate or as an agglomerate (like a bunch of grapes).
According to this recommended definition, a nanomaterial is “a natural, incidental or manufactured material containing particles, in an unbound state or as an aggregate or as an agglomerate and where, for 50 % or more of the particles in the number size distribution, one or more external dimensions is in the size range 1 nm - 100 nm”. Georges Favre adds, another good indicator for defining a nanomaterial is the volume-specific specific surface area (VSSA). "As long as the VSSA is greater than 60 m2/cm3 - although the reciprocal is not necessarily true, as nanomaterials can have a VSSA below this threshold value." To support this new and complex obligation for industry, in September 2019 the European Commission's Joint Research Centre published An overview of concepts and terms used in the European Commission’s definition of nanomaterial to make related terms and concepts clearer. See the report here.
However, the definition used by the food industry is Regulation No. 2283/2015 (Novel Food) which does not mention criteria for percentage of nanoparticles present in the substance, but a notion of intentionality of production. “Any material intentionally produced with one or more dimensions of the order of 100 nm or less, or consisting of separate functional parts, either internal or surface, many of which have one or more dimensions of the order of 100 nm or less, including structures, agglomerates or aggregates that may be larger than 100 nm but retain typical nanoscale properties (i.e. totally unique properties related to very small particle size or property related to the large specific surface area of nanoparticles).”
The limitations of current techniques
Many techniques exist to measure size distribution of particle samples. (DLS, A4F-MALS, sp-ICPMS, CLS, SMPS, NTA, MEB, MET, AFM, PTA, etc.). “However, none of them are perfect yet. Different techniques produce different results,” explains Georges Favre.
Limitations due to intensity of distribution of nanoparticles
Most techniques provide size distributions in intensity, mass or volume depending on the physical principle used to detect particles. But such distribution leads to a reduction in the real proportion of potentially present nanoparticles, contrary to results expressed in terms of particle size distribution.
Limitations due to nanoparticle forms
Most analytical techniques are based on the assumption that the particles are spherical, which obviously tends to bias the results when they aren’t. “Incorrect conclusions can even be drawn from such (false-negatives),” Georges Favre confirms.
Limitations due to cluster grouping of nanoparticles
"Finally, agglomeration/aggregation of particles has a large impact on results, since information on the size of the constituent particles or the internal structure of the objects present (agglomerates/aggregates) must be available.”
Nano-objects are very often clustered. If the sample has not been prepared correctly many analytical techniques see the size of the agglomerates/aggregates and not the size of the constituent particles.
Limitations due to nanoparticle size
"The smallest external dimension of particles must also be accessible to meet the requirements of European definitions for nanomaterial," adds Georges Favre.
"But apart from electron microscopy, the resolution of most techniques in terms of minimum accessible size is a few nanometres, even tens of nanometres, and therefore does not correspond to the nanometre scale required, which is between 1 and 100 nm. This means that these techniques cannot see very small particles in the sample.”

What’s at stake? Beware of incorrect labelling!
“Many manufacturers consult us completely unaware that their product contains ingredients considered to be nanomaterials. Very often, techniques used by their suppliers are not adapted to the substances tested, and data is unsubstantiated. This results in false labelling and misinformation for consumers. We had a case recently with titanium dioxide (E171). The company believed, in good faith, that the additive in its product did not contain nanoparticles based on data provided by their supplier. Scanning electron microscopy (SEM) performed at LNE showed that almost 50% of the particles of this titanium dioxide were actually nanoparticles (< 100nm). This was because the supplier’s laboratory had not used an appropriate technique for seeing the nanoparticles in the sample!”
How can the food industry be sure to comply with regulations and ensure reliable communication for consumers, which is, after all, the key to retaining their trust?
LNE recommendations
Each substance has its own technique
Criteria for size, chemical composition, shape, agglomeration/aggregation status, etc. "The choice of the technique to be used depends on the physicochemical characteristics of the substance being analysed," explains Georges Favre.
The first criteria to be taken into account is the number of sizes of constituent particles in a substance, whether they are isolated or grouped into agglomerates/aggregates. For example, he likens the particles to grape seeds in a bunch of grapes. The second criteria: the shape of the particles. “Shape plays an essential role in the choice of techniques and must be identified before analysis.”
You can download here a summary (in French) of the different techniques available for different substances.
Good to know: the NanoDefiner e-tool, a free resource available online helps to identify relevant techniques for different substances, as well as techniques to be avoided.
Multiple techniques: electron microscopy and screening
On the basis of the results of the NanoDefine project, European authorities recommend that the results from analytical techniques be crossed.
The characterisation of a substance using at least two techniques is the accepted minimum, including electron microscopy (scanning electron microscopy/SEM or transmission electron microscopy/TEM). Georges Favre says, "Electron microscopy is considered to be the benchmark technique and should be used in addition to screening methods."
Validate your protocol
The implementation of validated and harmonised protocols is also vital, particularly for sample preparation and data processing. Otherwise results are difficult to compare, even when using electron microscopy techniques.
"Initiatives are underway, in France with the NANOMET project and Europe with nPSize, to advance these issues and communicate best practices," says Georges Favre.
"In the meantime, the use of expert laboratories for this type of complex analysis is the best way to ensure quality data," he adds. "The EC4SafeNano initiative (European Centre for Risk Management and Safe Innovation in Nanomaterials & Nanotechnologies), which counts the LNE as an associate member, aims to map and evaluate expertise in Europe to help the food industry.”
Keywords
Nanomaterials, INCO regulation, analytical technique, controlled substances, labelling, precautionary principle
|
Go further...To find out more about nanomaterials in food, or LNE's areas of expertise, contact Elodie da Silva: elodie.dasilva@vitagora.com
A food engineer from the French city of Toulouse, Elodie leads the "Innovation & Ecosystem" team of Vitagora in providing support for agrifood business innovation goals, with enthusiasm, professionalism and confidentiality. |
Further reading
- Characterising nanomaterials
- A technique-driven materials categorisation scheme to support regulatory identification of nanomaterials, Gaillard et al., Nanoscale Adv. 2019, 1, 781
- Challenges in sample preparation for measuring nanoparticles size by scanning electron microscopy from suspensions, powder form and complex media, Bouzakher Ghomrasni et al., Powder Technology, 2020, 359, 226
- Reliable nanomaterial classification of powders using the volume-specific surface area method, Wohlleben et al, J Nanopart Res 19:61, 2017




 Home
Home



















